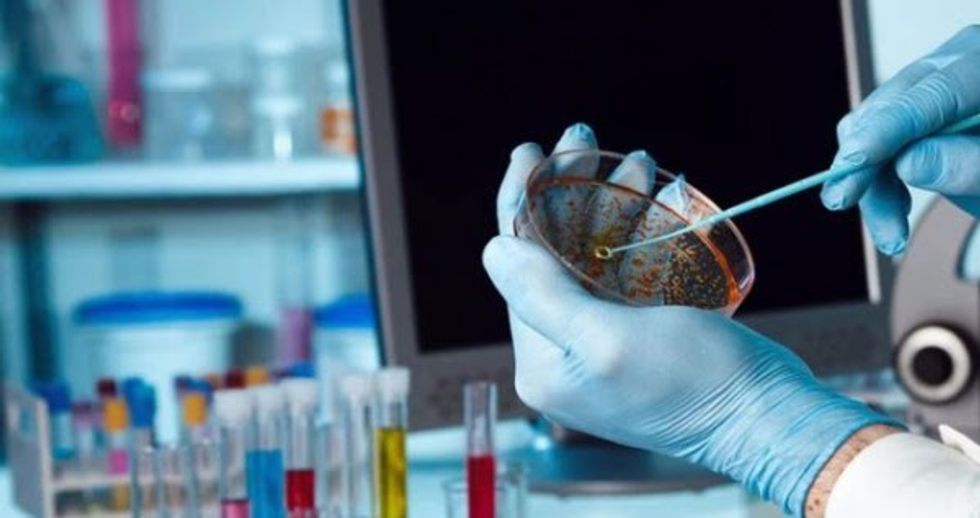
unnamedd

COVID-19, ilaçe antivirale si plotësues të vaksinave kundër varianteve të reja

Investim në kërkimin e ilaçeve të reja antivirale për të bllokuar përsëritjen e virusit SarsCoV2, “motori” i vërtetë që gjeneron variante të reja: kjo është strategjia plotësuese e asaj të vaksinave, që mund të jetë vendimtare në kontrollin e pandemisë në nivel global, sipas ekspertëve
“Viruset, zakonisht, përdorin dy strategji për t’u përhapur: ato mund të rrisin transmetueshmërinë e tyre ose mund të përpiqen t’i shpëtojnë mbrojtjes imune”, shpjegon Francesco Broccolo, virolog në Universitetin Bicocca të Milanos.
“Deri më tani, SarsCoV2 ka përdorur kryesisht strategjinë e parë, duke zhvilluar variante gjithnjë e më ngjitëse, por tani rruga e tij evolucionare mund të jetë në një pikë kthese: presioni selektiv i ushtruar nga antitrupat e zhvilluar nga të shëruarit dhe të vaksinuar mund ta nxisë atë të ndryshojë strategji dhe të zgjedhë ato mutacionet që e lejojnë atë t’i shpëtojë sistemit imunitar”, shtoi ai.
“Mutacionet lindin nga “një proteinë virale, që kopjon gjenomin e virusit gjatë replikimit me efikasitet të dobët, duke futur gabime të rastësishme”, tha Massimo Zollo, gjenetist në Universitetin “Federico II” dhe kreu i task forcës COVID-19 të CEINGE-Bioteknologjive të Avancuara në Napoli.
“Për të ndaluar këtë ruletë ruse, para se të shfaqen mutacione të rrezikshme, ne duhet të gjejmë frenues të rinj të aftë për të bllokuar replikimin viral. Prandaj ne duhet t’i japim një shtysë të re kërkimit të barnave të reja antivirale, të braktisura disi pas dështimeve të remdesevir”, vë në dukje Zollo.
Një tjetër pistë për t’u ndjekur ka të bëjë me “studimin e gjeneve pritëse, që rrisin mundësinë e zhvillimit të formave të rënda të COVID-19: në të ardhmen ata mund të na ndihmojnë të identifikojmë pacientët në rrezik, për t’i trajtuar herët me antitrupa monoklonalë ose ilaçe kundër stuhisë inflamatore”